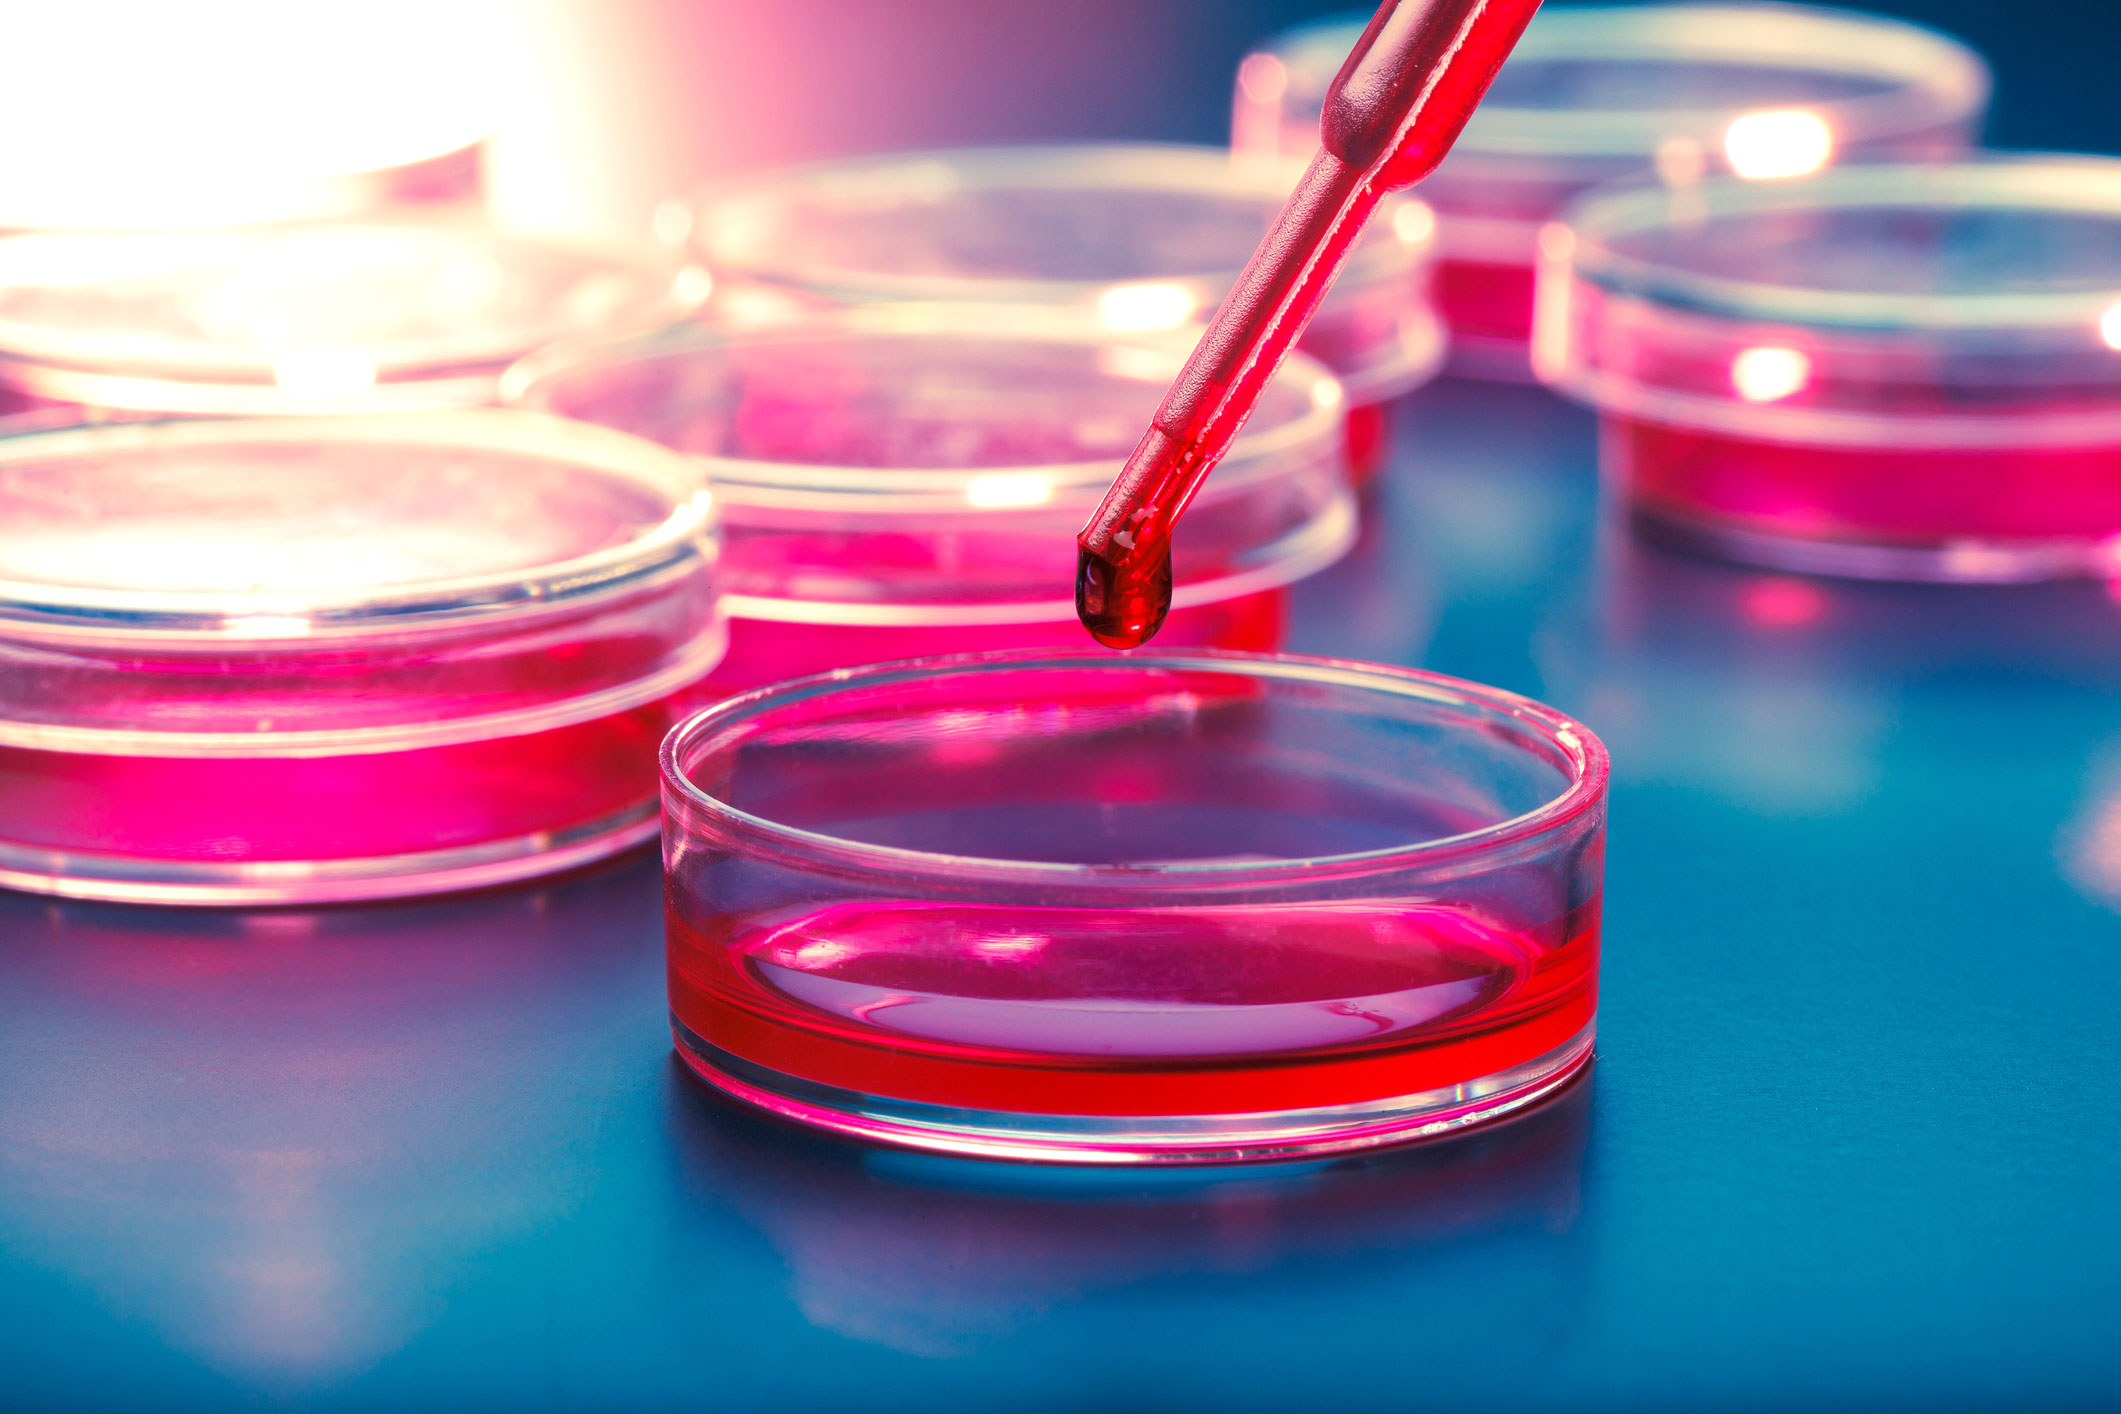

In Italia sono circa 3mila le persone sopra i 70 anni che vengono colpite da una sindrome mielodisplastica, nota anche come mielodisplasie: sono patologie del sangue dovute al danneggiamento di una delle cellule staminali del midollo osseo e sono caratterizzate da una carenza delle cellule del sangue. Le cellule staminali danneggiate, infatti, non riescono a produrre una quantità adeguata di cellule del sangue funzionali, con conseguente carenza di globuli rossi, globuli bianchi e/o piastrine. In alcuni casi, le sindromi mielodisplastiche si trasformano in leucemia mieloide acuta. Ne ha parlato in un’intervista del Corriere della Sera il Prof. Matteo della Porta, Responsabile di sezione leucemie e mielodisplasie in Humanitas e professore di Ematologia in Humanitas University.
In occasione della Giornata Mondiale della Consapevolezza sulla patologia, l’Associazione Italiana Pazienti con Sindrome Mielodisplastica (AIPASIM) e Fondazione Italiana Sindromi Mielodisplastiche (FISM) hanno celebrato l’evento con il convegno scientifico «Le sindromi mielodisplastiche: attualità nell’approccio clinico» a Milano. L’obiettivo del convegno è stato quello di condividere le conoscenze sul tema, di discutere le implicazioni cliniche delle nuove acquisizioni biologiche, di fornire linee guida pratiche per migliorare il processo diagnostico e di conseguenza la scelta terapeutica migliore per i pazienti.
I sintomi delle mielodisplasie
“I sintomi più rilevanti che si manifestano all’esordio della malattia — ha spiegato Matteo della Porta, Responsabile di sezione leucemie e mielodisplasie in Humanitas e professore di Ematologia in Humanitas University — sono l’anemia, che è presente in tutti i pazienti e che è causa di stanchezza, mancanza di resistenza fisica, tachicardia e crampi alle gambe, la piastrinopenia che può causare emorragie e la leucopenia che può provocare infezioni ricorrenti”. “Nelle fasi più avanzate la malattia incide sulla funzionalità di diversi organi, come il cuore e l’ apparato circolatorio in primis – ha aggiunto il Prof. Della Porta – generando ulteriori complicanze che riducono l’aspettativa di vita dei pazienti. Clinicamente sono patologie estremamente eterogenee: si va da pazienti che hanno la stessa aspettativa di vita della popolazione generale della stessa età, a casi che, invece, hanno una rapidissima evoluzione in leucemia acuta nel giro di pochi mesi. I pazienti hanno necessità assistenziali specifiche, e si rende quindi necessario lo sviluppo di percorsi di diagnosi, terapia e assistenza sanitaria mirati”, ha concluso Della Porta.
Le Reti di patologia: condividere per prevenire e combattere la malattia
Come è stato sottolineato anche in occasione del convegno scientifico il ruolo delle Reti di patologia è fondamentale per lo scambio delle informazioni sulle migliori pratiche e per l’aggiornamento scientifico. Grazie al lavoro delle reti è stata completata la prima mappatura di queste patologie in Italia, attraverso il collegamento di tutti i registri di malattia presenti sul territorio nazionale. Sono dati incrociati utili a sviluppare politiche sanitarie appropriate e sostenibili.
Nuovi trattamenti mirati
“Il contrasto alla malattia si caratterizza oggi su due livelli diversi di approccio – ha spiegato il Prof. Della Porta -: quello relativo ai pazienti il cui problema principale è l’insufficienza midollare e con un basso rischio di progressione leucemica, in cui gli sforzi terapeutici devono essere rivolti alla correzione dell’anemia” e il “segmento invece del 20-25% dei casi nei quali la malattia è più aggressiva e in cui la terapia deve essere mirata ad evitare la progressione leucemica”. “Nei casi relativamente più giovani il trapianto di cellule staminali emopoietiche rappresenta una concreta possibilità di cura, mentre nei pazienti non eleggibili al trapianto, disponiamo di un numero crescente di farmaci che possono controllare efficacemente la malattia e migliorare qualità e aspettativa di vita. Oggi le sindromi mielodisplastiche sono una delle patologie ematologiche per cui sono disponibili più trattamenti innovativi”, ha concluso il professore.
Visite ed esami
-
2.3 milioni visite
-
+56.000 pazienti PS
-
+3.000 dipendenti
-
45.000 pazienti ricoverati
-
800 medici